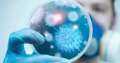
أعلنت وزارة الصحة ومنظمة...

الصحة توجه نصائح للمواطنين للحماية من العاصفة دانيال
وجه الدكتور حسام عبدالغفار المتحدث باسم وزارة الصحة نصائح للحماية من المضاعفات الصحية الناتجة عن التقلبات الجوية وتزامنا مع العاصفة دانيال.
نصائح للمواطنين للحماية من العاصفة دانيال
وقال المتحدث الرسمي لوزارة الصحة إن مرضى حساسية الصدر الذين يعانون من ضيق تنفس أو مشكلات في الشعب الهوائية عليهم تجنب الخروج من المنزل إلا في حالات الضرورة.
ونصح بضرورة ارتداء الكمامة أثناء الخروج من المنازل في وجود العاصفة الترابية تجنبا لدخول الأتربة إلى الشعب الهوائية.
Advertisements
كما نصح بالجلوس في الأماكن جيدة التهوية والابتعاد عن الأماكن المزدحمة.
شرب كميات من المياه لا تقل عن 2 لترفي اليوم
وتضمنت النصائح شرب كميات من المياه لا تقل عن 2 لترفي اليوم لتحسين تدفق الدم إلى الرئتين والإهتمام بنظافة أرضيات المنزل وجميع الأسطح ومسحها بالمنظفات والمطهرات وكذلك تناول مرضى الحساسية للأدوية في مواعيدها وفقا لإرشادات الطبيب.
وأكد المتحدث الرسمي لوزارة الصحة انه في حالة الشعور بأي أعراض مرضية او تنفسية
استشر الطبيب المختص.
وحذرت هيئة الأرصاد الجوية من حالة من عدم الاستقرار في الأحوال الجوية بدأت من اليوم الإثنين علي غرب البلاد وتمتد الثلاثاء والأربعاء إلى مناطق من شمال البلاد.
أول منخفض جوى فى الخريف
تتأثر البلاد بمنخفض جوي في طبقات الجو العليا مع منخفض جوي متعمق علي سطح البحر المتوسط يصاحبه تكاثر للسحب المنخفضة والمتوسطة والرعدية والتي يصاحبها سقوط أمطار متوسطة قد تكون غزيرة ورعدية أحيانًا على مناطق من السلوم ومطروح وسيوة.
وتمتد الأمطار خفيفة في المساء إلى مناطق من الإسكندرية قد تكون متوسطة أحيانًا.
خريطة الأمطار الرعدية
وأعلنت هيئة الأرصاد الجوية، أنه يوم الثلاثاء يستمر سقوط الأمطار المتوسطة والرعدية أحيانًا علي مناطق متفرقة من السواحل الشمالية الغربية وشمال الوجه البحري.
وتصل الأمطار تدريجيا للداخل لتؤثر على مناطق من جنوب الوجه البحري ومدن القناة ولكنها أمطار خفيفة قد تكون متوسطة وتمتد الأمطار الخفيفة الي مناطق من القاهرة الكبرى.
ويقل سقوط الأمطار يوم الأربعاء لتكون الأمطار خفيفة قد تكون متوسطة علي مناطق من السواحل الشمالية وشمال الوجه البحري ومدن القناة، تمتد خفيفة إلى مناطق من جنوب الوجه البحري وخليج السويس ووسط سيناء.
ونقدم لكم من خلال موقع (فيتو)، تغطية ورصدًا مستمرًّا على مدار الـ 24 ساعة لـ أسعار الذهب، أسعار اللحوم ، أسعار الدولار ، أسعار اليورو ، أسعار العملات ، أخبار الرياضة ، أخبار مصر، أخبار اقتصاد ، أخبار المحافظات ، أخبار السياسة، أخبار الحوداث ، ويقوم فريقنا بمتابعة حصرية لجميع الدوريات العالمية مثل الدوري الإنجليزي ، الدوري الإيطالي ، الدوري المصري، دوري أبطال أوروبا ، دوري أبطال أفريقيا ، دوري أبطال آسيا ، والأحداث الهامة و السياسة الخارجية والداخلية بالإضافة للنقل الحصري لـ أخبار الفن والعديد من الأنشطة الثقافية والأدبية.